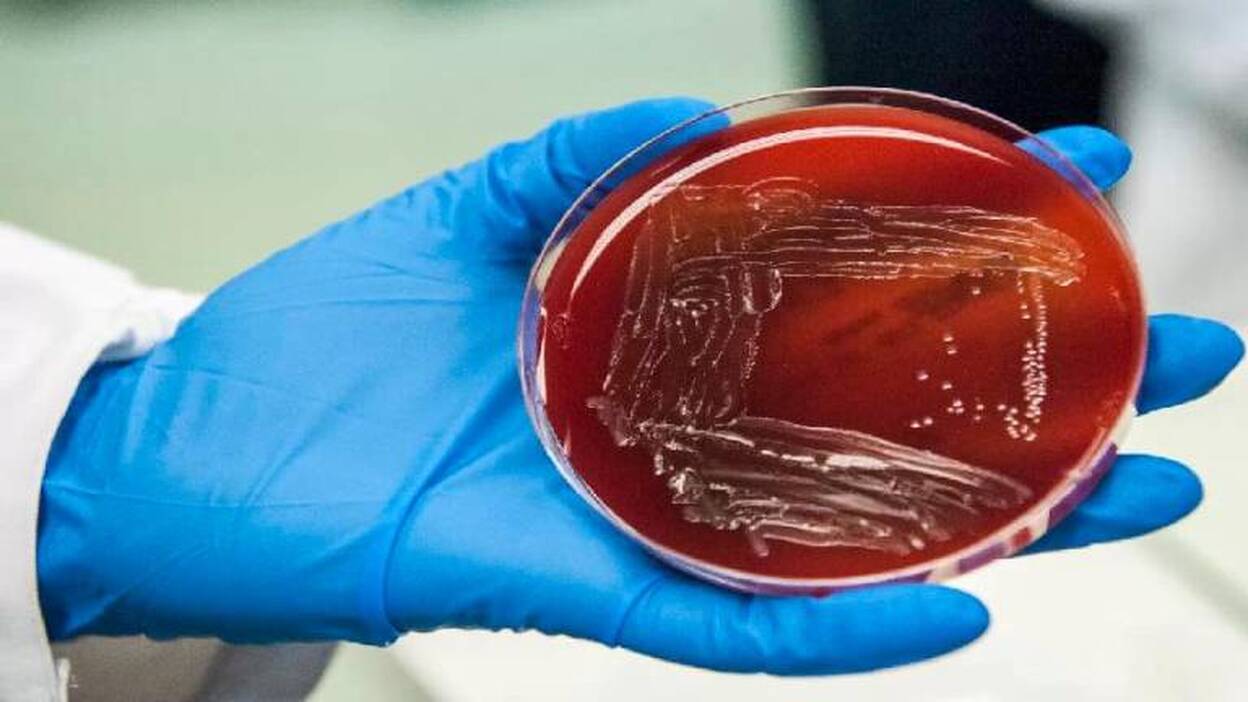
España registra unas 25 muertes al año por listeria

España registra unas 25 muertes al año por listeria
En España, en los últimos años, se ha registrado un promedio de 25 muertes al año por listeria, una bacteria peligrosa y resistente que causa la enfermedad de la listeriosis si se digiere viva y cuyo periodo de incubación puede llegar a los 70 días.
Efe / Madrid
Jueves, 22 de agosto 2019, 14:04
Una cifra aportada por el Ministerio de Sanidad que en su web de la Agencia Español de Seguridad Alimentaria y Nutrición (Aesan) recuerda que, pese a ser poco frecuente en los seres humanos, la listeriosis suele ser grave, con altas tasas de hospitalización y mortalidad.
En 2017, hubo 2.480 casos de listeriosis en humanos en la Unión Europea, con 227 muertes en 16 Estados miembros, lo que implica una tasa de mortalidad del 13,8 %. En España, en ese mismo año, hubo 284 casos confirmados.
Entre los casos más recientes se encuentran las dos muertes ocurridas en Francia el pasado mayo por consumir queso contaminado con listeria o las cinco personas que fallecieron en junio en Reino Unido por comer sandwiches y ensaladas afectados por la misma bacteria en hospitales de una región de ese país.
El pasado día 20, el Sistema de Alerta Rápida para Alimentos y Piensos de la Unión Europa (RASFF en sus siglas en inglés) registró el brote de listeriosis iniciado en Sevilla como una alerta sanitaria a tener en cuenta en toda la UE.
Y es que ante la posibilidad de que se identifiquen casos en otros países, Sanidad hizo las comunicaciones necesarias al Sistema de Alerta Precoz y Respuesta de la Unión Europea y a la Organización Mundial de la Salud (OMS)
Fuentes del Ministerio de Sanidad han explicado que la comunicación a la UE y a la OMS forma parte del protocolo habitual en estos casos y más si se tiene en cuenta que España es destino turístico de muchas personas que pudieron ingerir alguno de los alimentos contaminados y, posteriormente, haber regresado a su país.
Se trata de un procedimiento habitual cuando se produce un brote de cualquier enfermedad en alguno de los estados miembros de la UE, han precisado.
Además, España ha informado a la Comisión Europea (CE) de que la carne que ha causado el brote de listeriosis solo se vendió en el territorio nacional y de que ya se han adoptado las "medidas necesarias" en este tipo de casos, según ha explicado este jueves la portavoz comunitaria Anca Paduraru.
"La Comisión Europea está al corriente del brote en relación con el consumo de carne. Estamos en estrecho contacto con las autoridades españoles y seguimos la evolución de la situación", ha añadido.
Se trata de una medida de precaución ante este brote de listeriosis, ha dicho este jueves la ministra de Sanidad, María Luisa Carcedo, quien ha avanzado que el origen del brote de intoxicación alimentaria por listeria se encuentra en la fábrica de la empresa Magrudis, en Sevilla, donde se elaboró la carne mechada, con la que se han contaminado al menos 150 personas y ha causado el fallecimiento de una mujer de 90 años.